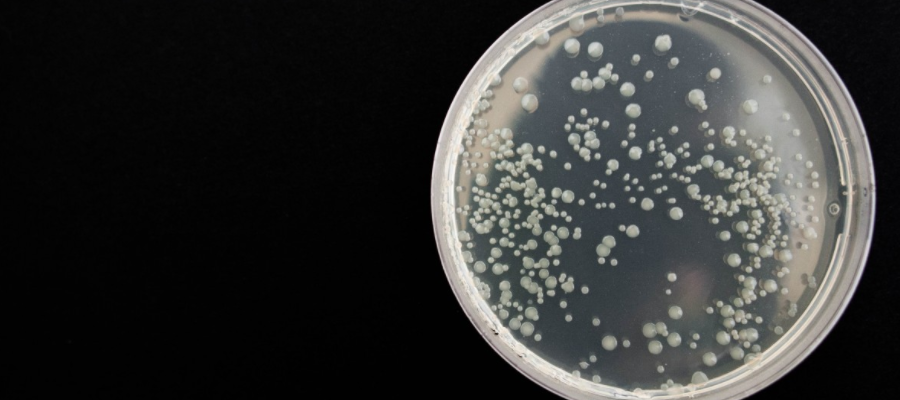

유렉스 프로바이오틱스란?
유렉스 프로바이오틱스는 UREX 프로바이오틱스라고도 불립니다. 과학자들은 인구의 건강과 수명 연장을 위하여 건강에 도움이 되는 약품과 유산균을 끊임없이 개발 해 내고 연구 하는 과정을 거치고 있는데요. 유렉스 프로바이오틱스도 이러한 과정에서 개발 된 유산균주 중 하나로, 2014년에 처음으로 개발, 인정 되었습니다. 특히 여성에게 유렉스 프로바이오틱스 효능이 도움이 된다고 알려 진 만큼, 여성질환으로 오랜 시간 고생 하고 있었다면 아래 내용을 꼼꼼히 읽어 보면 도움이 될 것으로 보입니다.
유렉스 프로바이오틱스 효능
UREX 프로바이오틱스는 유산균 증식을 통하여 여성의 생식기관 건강에 도움을 줄 수 있다는 것이 주된 기능입니다. 건강한 여성의 신체에 서식하는 균을 분리하여 여성의 생식기관과 장을 건강하게 관리 할 수 있도록 환경을 만들어 주는 역할을 하는데요. 특히 요즘은 레깅스 등 딱 달라붙는 옷을 입는 분들이 많은 만큼 염증이 자주 발생할 수 있어 유렉스 프로바이오틱스 효능이 도움이 될 것 입니다.
이러한 내용으로 인체 시험을 시행하여 질염 현상이 개선되고, 재발 또한 감소 되는 것을 확인 한 만큼 유렉스 프로바이오틱스 효능이 여성 건강에 좋다는 것 자체는 의심할 여지가 없어 보입니다. 또 이러한 실험 결과는 SCIe급 논문에도 다수 발표 되었는데요. SCI급은 아니지만 SCIe급에 활발하게 논의가 되고 있는 만큼 상당히 신뢰도가 높다고 할 수 있을 것 입니다.

유렉스 프로바이오틱스 부작용
다만 영유아나 임산부, 수유부의 경우 유렉스 프로바이오틱스 부작용이 있을 수 있기 때문에 섭취에 주의가 필요 하다고 하는데요. 영유아, 임산부, 수유부에 대하여 충분한 연구가 이루어 진 경우에는 섭취에 대하여 큰 우려가 없지만 현재는 UREX 프로바이오틱스가 허가 받은 날로부터 오랜 시간이 지나지 않았으므로 UREX 프로바이오틱스 부작용을 피하기 위해서는 의료진과 충분히 상담 한 다음 섭취 하는 것이 좋겠습니다.
또한 알러지가 있는 체질인 분, 기저질환이 있어 약물 복용에 주의를 해야 하는 분들도 반드시 유렉스 프로바이오틱스 부작용을 피할 수 있도록 섭취 전 담당 의사와 충분한 상담을 하는 것이 중요합니다.